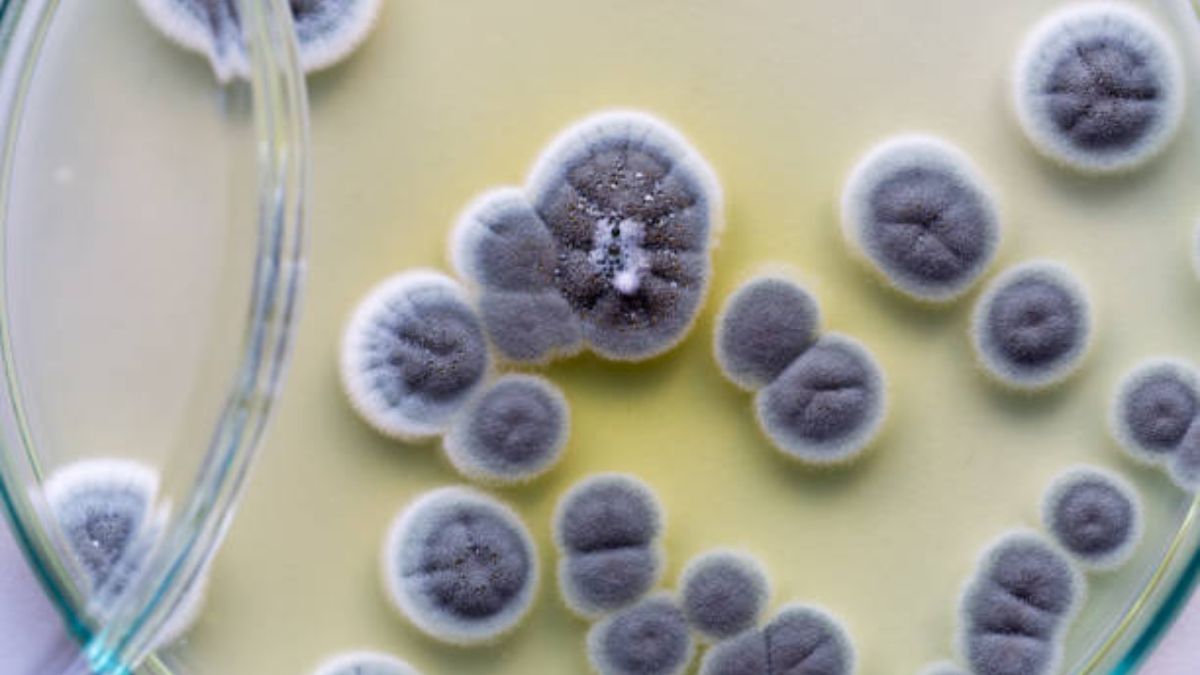

Todo descubrimiento científico es potencialmente capaz de tener un impacto profundo en la sociedad y la economía y de conducir a la superación de lo que, hasta entonces, siempre se había considerado límites insuperables. Repasemos a continuación, algunos de los avances científicos más importantes y averigüemos cuál ha sido el mejor avance científico de la historia y por qué.
Cuál ha sido el mejor avance científico de la historia y por qué
Saber cuál ha sido el mejor invento de la historia podría generar mucho debate ya que entre otras cosas, dependerá mucho de la época que deseemos considerar o valorar. Así por ejemplo, la locomotora, inventada en 1829 por el ingeniero británico Robert Stephenson, dio lugar al nacimiento del transporte ferroviario y permitió a muchas personas acceder a viajes más rápidos. Pero otros descubrimientos que tienen un carácter más científico también han servido para un avance de la humanidad en otros aspectos.
El descubrimiento de la penicilina
En este sentido, y según la opinión de los propios científicos, el avance de la ciencia que más habría marcado la historia sería el descubrimiento de la penicilina.
Descubierta por Alexander Fleming en 1928, la penicilina es un antibiótico elaborado a partir del hongo Penicillium notarum. Es eficaz contra numerosas bacterias, entre ellas estreptococos, estafilococos, espirilli y meningococos, incluso desafortunadamente su uso excesivo ha llevado a muchos microorganismos a desarrollar resistencia contra ella. Si Fleming fue el primero en descubrirlo, fueron Howard Walter Florey y Ernst Boris Chain quienes permitieron su producción industrial, hazaña por la que ganaron el Premio Nobel en 1945.
Gracias a este hallazgo, enfermedades como la neumonía, la tuberculosis, la meningitis y el tifus han dejado de aterrorizar a la humanidad porque encontraron una cura y se dio pie además a que se siguiera investigando para la creación de nuevos fármacos en forma de antibióticos.
La penicilina puede ser considerado el mayor avance científico de la historia, aunque como decimos, no sería el único. De hecho, queremos resaltar también estos otros dos que ahora os enumeramos.
El ADN
El ADN , el ácido nucleico que contiene toda la información genética necesaria para la biosíntesis de ARN y proteínas, fue aislado por primera vez por el bioquímico suizo Friedrich Miescher, quien advirtió la presencia de pus en algunos vendajes quirúrgicos utilizados. Más tarde, muchos otros investigadores contribuyeron al estudio del ácido desoxirribonucleico, incluidos James Watson y Francis Crick, quienes presentaron el primer modelo preciso de su estructura de doble hélice en 1953. El descubrimiento del ADN ha tenido importantes consecuencias en toda la comunidad científica, permitiendo, por ejemplo, descubrir el origen de algunas patologías a través de la biología molecular y desarrollar nuevas estrategias para tratarlas.
Rayos X
Los rayos X (también conocidos como rayos Roentgen) fueron descubiertos en 1895 por el físico alemán Wilhelm Konrad Roentgen: son radiación electromagnética caracterizada por longitudes de onda entre 10 nanómetros (nm) y 1/1000 de nanómetro (1 picómetro). Gracias a su capacidad para atravesar la materia, los rayos X se pueden utilizar en el campo médico en el tratamiento de ciertos tipos de tumores y para obtener radiografías.